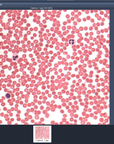

Check out our featured article!

Motic Images Plus 3.1 Advanced (Includes USB Dongle)
Motic Image Plus 3.1 Advanced is a professional and advanced imaging software that contains all the main features of our Motic Images Plus, with three additional modules added: Assembly, Multi-focus and Segmentation (superior counting module). It can capture, record video and create reports.
Motic Images Advanced has all of the features and tools of Motic Images Plus and much more.
Use this software package to analyze fluorescence images and segment images by RGB or Gray Scale.
Motic Images Advanced is packaged with Motic's Multi-Focus and Assembly programs that will accurately allow you to assemble images in a vertical or horizontal platform taking into account any overlap or shifting of images.
Segmentation
The superior counting module allows to perform manual segmentation by using a histogram (colour), grey scale or by selecting the size.
Assembly
This module can be used for creating a single overview image out of multiple separated images.
Multi-focus
The Multi-focus module can be used to capture up to 100 images taken at different focusing levels and assemble them into a new single image in focus.
Image Analysis
• Manual segmentation for data analysis
• Image Stacking with the Multi-focus software
• Image Stitching with Assembly software
How to connect your Moticam onto the trinocular tube
Learn how to connect your Moticam onto the trinocular tube easily.
New Motic Images Plus 3.0 Launch
A small taste of the Motic Images Plus 3.0 software.
Motic Images Plus 3.0 & 3.1 - First Steps tutorial
Learn how to make your first steps with Motic Images Plus 3.0 software. From software installation up to making professional measurements, we guide you step by step through getting a great live image, applying image adjustments to see the microscope's image as wished or the most closely to eyepiece observation, and capturing an image or video. All you might need to start with confidence.
Motic Images Plus 3.0 & 3.1 - Calibration tutorial
Calibration simply explained: Learn how to calibrate Motic Image Plus 3.0 software, a must in professional environments where exact scale and measurements are a daily need. Easy to follow step-by-step explanation with tips & tricks to perform it accurately.
At Motic Instruments, we take pride in the quality of our products and our user experience. That's why we offer technical advice and full post-sale support to keep your Motic products in optimal condition and ensure your microscopy results are of the highest quality. All of our microscopes are covered by a 5 year warranty on mechanical components and 1 year warranty on electrical components.